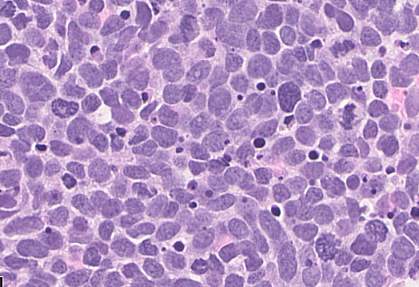

You are here
April 27, 2021
Targeted treatments for small-cell lung cancer
At a Glance
- A rapid screening process identified a two-drug combination that shrank small-cell lung tumors, which are often fatal within weeks of recurrence.
- In a pilot clinical trial, almost two-thirds of people who received the combination to treat recurrent small-cell lung cancer lived for at least six months.
About 13% of people with lung cancer have a type called small-cell lung cancer (SCLC). It’s one of the most aggressive and deadly tumor types, often proving completely resistant to chemotherapy. Even if SCLC shrinks after initial treatment, it can be fatal within weeks of recurrence.
Researchers have been searching for new ways to shut down the molecular processes that SCLC cells need to survive. A research team led by Drs. Anish Thomas from NIH’s National Cancer Institute (NCI) and Craig Thomas from NIH’s National Center for Advancing Translational Sciences (NCATS) used a rapid drug-screening process to test almost 2,500 approved and investigational cancer drugs. They looked for ones that suppressed cell growth in at least five of seven SCLC cell lines. Results were published on April 12, 2021, in Cancer Cell.
The screening identified more than 200 promising compounds. Notably, many interfered with the replication stress response. Cancer cells divide quickly, racing past the checkpoints that normal cells use to repair DNA damage. The accumulating damage is called replication stress. Replication stress response proteins respond to this damage.
The team next explored combinations of drugs with different targets in the replication stress response. They tested drugs in combination with TOP1 inhibitors, a type of chemotherapy drug currently used to treat recurrent SCLC. Drugs that blocked the cells’ natural DNA damage response were among those most likely to work, especially drugs that inhibit a protein called ATR.
In mice with SCLC tumors, the combination of an ATR inhibitor called berzosertib and a TOP1 inhibitor called topotecan limited tumor growth. Since this effect was seen at concentrations of the drugs known to be safe in people, the team rapidly moved the combination into a small clinical trial. Twenty-six people with SCLC that was growing after prior chemotherapy joined the study.
Nine participants experienced substantial reductions in tumor volume during treatment with the drug combination. Seventeen had some tumor regression. Participants lived for an average of 8.5 months after starting treatment, with some surviving for a year or more. These results exceeded those of current standard regimens.
The researchers also tested the drug combination in 10 people with related rare tumors called small-cell neuroendocrine cancers, which can arise in other organs such as the breast and bladder. Two of these participants had their tumors shrink substantially, and one of these responses lasted more than 8 months.
Using tissue samples taken before treatment, the researchers identified a set of molecular characteristics that were more likely to be found in those whose tumors shrank during the study. These may be useful to identify people most likely to benefit from future studies testing inhibitors of the replication stress response.
“Such large combination screening experiments can reveal pharmacologic relationships from an increasingly diverse collection of compounds and drugs,” says Craig Thomas. “In the best-case scenario, the outcomes of these screens can help clinical teams prioritize their efforts.”
A larger study to test the berzosertib-topotecan combination in people with SCLC is ongoing.
Related Links
- Treatments Linked to Drop in Lung Cancer Deaths
- Gene Changes Identified in Most Common Lung Cancer
- Gene Variations Linked to Lung Cancer in Non-Smokers
- CT Screening Significantly Reduces Lung Cancer Mortality
- Finding Compounds That Inhibit Zika
- Matrix Combination Screening
- Lung Cancer
- Stamp Out Smoking: Tobacco-Free Living
- Quitting Smoking
References: Therapeutic targeting of ATR yields durable regressions in small cell lung cancers with high replication stress. Thomas A, Takahashi N, Rajapakse VN, Zhang X, Sun Y, Ceribelli M, Wilson KM, Zhang Y, Beck E, Sciuto L, Nichols S, Elenbaas B, Puc J, Dahmen H, Zimmermann A, Varonin J, Schultz CW, Kim S, Shimellis H, Desai P, Klumpp-Thomas C, Chen L, Travers J, McKnight C, Michael S, Itkin Z, Lee S, Yuno A, Lee MJ, Redon CE, Kindrick JD, Peer CJ, Wei JS, Aladjem MI, Figg WD, Steinberg SM, Trepel JB, Zenke FT, Pommier Y, Khan J, Thomas CJ. Cancer Cell. 2021 Apr 12;39(4):566-579.e7. doi: 10.1016/j.ccell.2021.02.014. PMID: 33848478.
Funding: NIH’s National Center for Advancing Translational Sciences (NCATS) and National Cancer Institute (NCI).